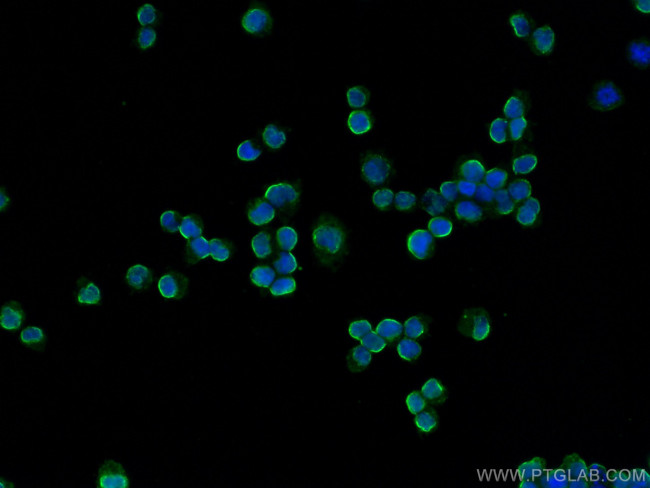
BLNK Antibody in Immunocytochemistry (ICC/IF)
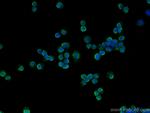
BLNK Antibody in Immunocytochemistry (ICC/IF)

Search
Proteintech
BLNK Monoclonal Antibody (1A1A1)
{{$productOrderCtrl.translations['antibody.pdp.commerceCard.promotion.promotions']}}
{{$productOrderCtrl.translations['antibody.pdp.commerceCard.promotion.viewpromo']}}
{{$productOrderCtrl.translations['antibody.pdp.commerceCard.promotion.promocode']}}: {{promo.promoCode}} {{promo.promoTitle}} {{promo.promoDescription}}. {{$productOrderCtrl.translations['antibody.pdp.commerceCard.promotion.learnmore']}}
产品信息
66953-1-IG
种属反应
宿主/亚型
分类
类型
克隆号
抗原
偶联物
形式
浓度
规格
纯化类型
保存液
内含物
保存条件
运输条件
产品详细信息
Aliquoting is unnecessary for -20°C storage.
靶标信息
B cell linker protein (Blnk) is a protein encoded by the Blnk gene located on chromosome 10 in humans. It is also known as SLP 65 (Src homology 2 domain-containing leukocyte protein of 65 kDa). It derives its name from being an adaptor protein in the B cell receptor signaling cascade with several supporting studies showing improper development of B cells in the absence of Blnk. Blnk undergoes tyrosine phosphorylation by Syk, a B cell receptor activated kinase, which provides a platform for interaction of signaling intermediaries such as the Vav GEF and Grb2.
仅用于科研。不用于诊断过程。未经明确授权不得转售。
篇参考文献 (0)
生物信息学
蛋白别名: B cell adaptor containing SH2 domain; B-cell activation; B-cell adapter containing a SH2 domain protein; B-cell adapter containing a Src homology 2 domain protein; B-cell linker protein; Cytoplasmic adapter protein; MGC111051; SLP-65; Src homology 2 domain-containing leukocyte protein of 65 kDa; Src homology [SH2] domain-containing leukocyte protein of 65 kD; unnamed protein product
基因别名: AGM4; BASH; bca; BLNK; BLNK-S; LY57; SLP-65; SLP65
UniProt ID: (Human) Q8WV28
Entrez Gene ID: (Human) 29760, (Pig) 100152350